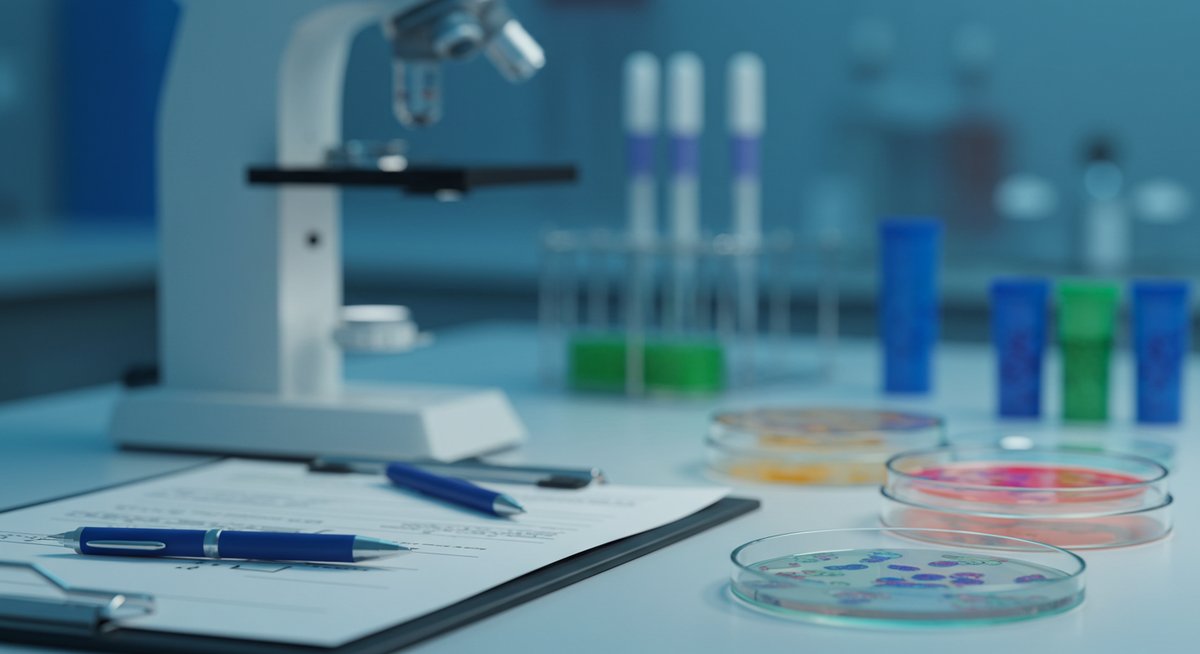

あたらない牡蠣をお探しの方に朗報!
海洋深層水で浄化された安心・安全な生牡蠣
ホタルイカの沖漬けは風味豊かで人気がありますが、生のままだと寄生虫や細菌のリスクが気になります。ここでは、家庭で購入・調理・保存するときに押さえておきたいポイントを分かりやすくまとめます。安全に食べるための下処理や見分け方、万が一の症状への対応まで、実践しやすい情報をお伝えします。
ホタルイカの沖漬けは危ないのか食べる前に押さえる点

ホタルイカ自体は美味しい食材ですが、沖漬けの形で食べるときは特に注意が必要です。生のまま漬けるため、内臓に潜む寄生虫や表面の細菌が漬け汁を通じて広がることがあります。購入前や調理前に鮮度や処理の有無を確認することでリスクを下げられます。
市販の加工品ならば製造工程で処理されている場合が多く安心度は上がりますが、未加工の生ホタルイカを自家製で沖漬けにする場合は下処理や冷凍処理、加熱などの対策が重要です。特に内臓を残したままだとリスクが高まるため、内臓除去の手順を守ってください。
また、保存方法も大切です。低温管理が不十分だと細菌が増殖しやすくなります。簡単にできるチェック項目を覚えておくと、購入後すぐに安全確認ができます。
生の沖漬けは寄生虫リスクがある
生の沖漬けに使うホタルイカには、内臓に寄生する種類の寄生虫がいることがあります。これらは加熱や凍結をしない状態だと人に感染する恐れがあり、消化器症状やアレルギー反応を引き起こすことがあります。
見た目では判断しにくいため、内臓をきちんと取り除くことや、少なくとも規定の温度で凍結するなどの対策が有効です。特に家庭での生食はリスクが高く、免疫力が低い人やお年寄り、子どもは避けたほうが安全です。
もし生で提供された沖漬けを食べる場合は、販売元がどのような処理を行っているか確認することをおすすめします。処理記載があればリスクが下がりますが、記載がなければ加熱や凍結で自ら安全性を高めてください。
市販品は処理でリスクが下がる
市販の沖漬け製品は、製造段階で内臓除去や凍結処理、衛生管理が行われていることが多く、家庭で生のまま作るより安全性が高い傾向にあります。パッケージに「加熱済み」「急速凍結済み」などの表示があるかを確認しましょう。
また、信頼できるメーカーや販売店は衛生管理やトレーサビリティを明示している場合が多いです。原材料表記や製造日、保存方法を確認すると安心です。
一方で、無表示の生鮮品や市場で直接買う場合は処理状況が不明なことがあるため、自宅での下処理や冷凍を必ず行うなど追加の対策が必要になります。購入時は鮮度と処理情報を確認してください。
凍結や加熱で安全性が高まる
寄生虫や一部の細菌は一定の温度で死滅します。寄生虫対策としては-20℃以下で24時間以上の冷凍や、中心温度が75℃以上で一定時間保つ加熱が有効とされています。家庭用冷凍庫でも急速冷凍機能があれば効果的です。
ただし、酢や酒で漬けただけでは寄生虫が完全に死なないことがあるため、風味を保ちつつ安全を確保したい場合は冷凍後に解凍して漬けるか、軽く加熱してから漬ける方法がおすすめです。加熱すると食感や風味が変わるため、好みに合わせて調整してください。
常温で長時間放置すると細菌が増えるので、調理後はすぐに冷蔵または冷凍保存してください。保存期間を守ることも重要です。
内臓を残すと危険度が上がる
ホタルイカの内臓には寄生虫や細菌の温床になりやすい成分が含まれるため、内臓を残したまま沖漬けにするとリスクが高まります。特に未処理の内臓は漬け汁を通して全体に広がるため、必ず取り除くことが大切です。
内臓の取り方は簡単な手順で行えますが、内臓を触った手で他の部分に触れないよう注意してください。作業後はまな板や包丁をよく洗浄・消毒してください。
内臓を使った加工品や珍味は別ですが、沖漬けとして食べる場合は内臓を除去した上で凍結や加熱処理を行うと安全性が飛躍的に向上します。
異変があれば速やかに医療機関へ
食後に腹痛、激しい吐き気、下痢、発熱、呼吸困難、発疹などの異常が出た場合は、早めに医療機関で受診してください。症状の内容によっては感染症やアレルギー反応の可能性があり、適切な検査と治療が必要です。
受診時にはいつ、どのようなものを食べたか、購入元や保存・調理方法について伝えると診断がスムーズになります。特に血便や脱水などが見られる場合は緊急性が高まるため速やかな受診をおすすめします。
また、家庭での保存状況や購入ロットが把握できると、他の同ロットの製品を回収・確認する際に役立ちます。症状が軽くても不安なら医療機関に相談してください。
沖漬けが危険になる主な原因

沖漬けが危険になるのは、主に寄生虫・細菌・不十分な処理の3つが絡むためです。漬け汁がそれらを全体に広げ、低温管理が不適切だと増殖しやすくなります。加えて、内臓を残したまま漬けると危険度がさらに上がります。
漬け方や保存方法、原料の鮮度が安全性を左右します。素材の管理や処理をしっかり行えばリスクは大幅に下がるため、家庭でもできる対策を把握しておくことが大切です。
寄生虫の種類と発生場所
ホタルイカに見られる寄生虫は、主に消化管や肝臓など内臓に潜むタイプが多いです。外見では分かりにくいため、内臓に寄生していることを前提に処理することが必要です。
寄生虫は海域や季節によって発生率が異なる場合がありますが、完全にゼロにすることは難しいため、内臓除去や冷凍処理でリスクを減らす対策が重要です。漁獲後の処理がどう行われているかを確認することも役立ちます。
細菌の増殖と食中毒の危険
ホタルイカは水分が多く、漬け汁での保存状態が悪いと細菌が増殖しやすくなります。特に常温で放置すると短時間で増殖し、食中毒の原因になります。
保存は冷蔵や冷凍で行い、開封後は早めに消費することが基本です。調理器具や手指の衛生管理を怠ると二次汚染も起こるため、清潔な環境で作業してください。
漬け汁で寄生虫が生き残る可能性
酢や酒を使った漬け汁は風味を和らげますが、必ずしも寄生虫を死滅させるわけではありません。寄生虫の種類によっては酸やアルコールに耐える場合があるため、漬け汁だけに頼らず冷凍や加熱での対策が必要です。
特に短時間の漬け込みや低濃度の調味料では効果が薄いので注意してください。安全性を重視するなら、漬ける前に適切な処理を行いましょう。
処理不足や鮮度低下がリスクを高める
漁獲後の処理が遅れると細菌や寄生虫のリスクが高まります。鮮度が落ちると食感や風味も損なわれますし、微生物の増殖も促進されます。
購入時には製造日や消費期限、保存状態を確認し、家庭でも速やかに処理・保存してください。冷蔵のみで長期保存するのは避け、必要なら冷凍保存を選んでください。
酢や酒だけでは寄生虫が死なないことがある
酢漬けや酒漬けの風味付けは寄生虫対策として不十分な場合があります。酸やアルコールは一部の微生物に効果がありますが、寄生虫の種類や濃度・漬け時間によっては生存することがあります。
そのため、生食を避ける、冷凍処理を行う、あるいは十分な加熱をするなど別の対策を併用することが望ましいです。風味を保ちながら安全性を確保する方法を選んでください。
あたらない牡蠣をお探しの方に朗報!
海洋深層水で浄化された安心・安全な生牡蠣
寄生虫と細菌の症状と見分け方
寄生虫感染と細菌性食中毒は症状が重なることもありますが、発症の仕方や期間に違いがあります。症状の出方を把握しておくと、受診時に医師へ伝えやすくなります。以下の項目を目安にしてください。
急性の強い腹痛や発熱、吐き気がある場合は細菌性の可能性が高く、潜伏期間が長めで持続する腹痛や体調不良は寄生虫を疑う場合があります。もちろん個人差があるため、自己判断だけで放置せず医療機関で検査を受けることが重要です。
急な腹痛や嘔吐が出る場合の特徴
細菌性の食中毒では、食後数時間から十数時間で激しい腹痛や嘔吐、下痢が起こることが多いです。症状は急速に進行するため脱水に注意が必要です。
嘔吐や下痢が続く場合は水分補給を心がけ、改善が見られない場合や高熱、血便が出る場合は速やかに医療機関を受診してください。症状の重さによっては点滴治療が必要になることがあります。
皮膚症状や呼吸症状の注意点
寄生虫や細菌によっては発疹や掻痒感、じんましんのような皮膚症状を引き起こすことがあります。まれにアレルギー反応で呼吸困難や喉の腫れなど重篤な症状が出る場合もあるため、呼吸症状があるときはすぐに救急を受診してください。
皮膚症状が目立つ場合は、食べたものや既往のアレルギーを医師に伝えると診断の助けになります。
症状が出るまでの潜伏期間の目安
細菌性食中毒は数時間から24時間以内に発症することが多い一方、寄生虫感染は数日から数週間かけて症状が出ることがあります。寄生虫による慢性的な腹痛や栄養障害が出るケースもあります。
食べた日時と症状の開始時刻をメモしておくと、受診時に役立ちます。特に数日後に体調が変化した場合は寄生虫の可能性を考慮してください。
検査で確認される主な項目
医療機関では便の検査や血液検査、場合によっては内視鏡検査で寄生虫や細菌の有無を確認します。便培養や寄生虫卵の検査、炎症反応の有無を示す血液検査が一般的です。
早めに受診して検査を受けることで、適切な治療方針が立てやすくなります。検査結果は症状の種類や時間経過によって異なるため、医師の指示に従ってください。
感染時の治療の進め方
治療は原因に応じて行われます。細菌性の食中毒では抗菌薬や点滴での水分補給、寄生虫感染では駆虫薬が使われます。症状に応じて対症療法(鎮痛薬や制吐薬など)も行われます。
自己判断で市販薬を使うより、まずは医師に相談することが安全です。特に激しい症状や呼吸困難、血便、長引く発熱がある場合は速やかな受診が必要です。
安心の加熱用。初めてでも失敗なし!
ぷりっぷりの瀬戸内牡蠣、1.2kgの満足ボリューム!
家庭でできる安全な下処理と保存法

家庭で沖漬けを作るなら、購入時から下処理、保存までの手順を守ることが安全に楽しむポイントです。簡単で効果的な方法を覚えておくと安心です。
清潔な作業環境、内臓の確実な除去、必要に応じた冷凍または加熱処理、そして適切な保存温度と保存期間の管理が基本です。以下の見出しで具体的な手順を紹介します。
購入時に確認する鮮度チェック
購入時は目で見て表面がぬめらず、目が澄んでいるかを確認してください。強い生臭さや変色、ぬめりがある場合は鮮度が落ちている可能性があります。
パッケージ品なら製造日や消費期限、保存方法の表示を確認しましょう。市場や鮮魚店で買う場合は、店員に処理状況や漁獲日を尋ねると安心です。購入後は速やかに冷蔵または冷凍してください。
内臓を安全に取り除く具体手順
内臓除去は次の手順で行うと安全です。まず清潔なまな板と包丁を用意し、流水で外側の汚れを落とします。胴を軽く押して内臓を出し、ピンセットなどで丁寧に取り除きます。
作業中は手袋を使用すると衛生的です。内臓を触った後は器具や手を十分に洗浄・消毒してください。作業後はすぐに冷凍または加熱処理を行うと安全性が高まります。
冷凍の温度と日数の基準
寄生虫の対策としては-20℃以下で24時間以上凍結することが推奨されます。家庭用冷凍庫でも急速冷凍機能を使うか、小分けにして冷凍することで中心部まで凍結しやすくなります。
保存期間は冷凍であれば数週間から数か月が目安ですが、風味を保つためには長期保存を避け、できるだけ早めに消費してください。解凍は冷蔵庫内でゆっくり行うと品質低下を抑えられます。
加熱する際の目安温度と時間
加熱で安全性を高める場合、中心温度が75℃以上で一定時間保つことが推奨されます。具体的には短時間の加熱でも中心まで十分に温めることが重要です。
茹でる、蒸す、焼くなど好みの方法で調理できますが、加熱しすぎると食感や風味が変わるため、適度な温度管理を心がけてください。
沖漬けを作る際の安全な手順
安全に沖漬けを作る基本手順は次の通りです。まず鮮度の良いホタルイカを用意し、内臓を確実に取り除きます。その後、必要であれば-20℃以下で24時間凍結してから解凍します。
漬け汁は清潔な容器を使い、冷蔵庫で保存します。漬け込みも短時間にとどめ、長期間漬け置く場合は冷凍保存を検討してください。作業中は器具や手の衛生を徹底してください。
ホタルイカの沖漬けを安全に楽しむための簡単チェック
・購入時:目が澄んでぬめりがないか、製造日や保存表示を確認する。
・下処理:内臓は確実に除去し、手や器具を消毒する。
・凍結:可能なら-20℃で24時間以上の冷凍を行う。
・加熱:中心温度75℃以上を目安に調理する。
・保存:開封後は冷蔵短期、長期は冷凍で。異臭や変色があれば廃棄する。
これらをチェックすれば、ホタルイカの沖漬けをより安全に楽しめます。万が一体調不良が出たら、食べた日時や保存情報を伝えて速やかに医療機関を受診してください。
\買う前にチェックしないと損!/
今だけ数量限定クーポンをゲットしておいしいものをたっぷり食べよう!
